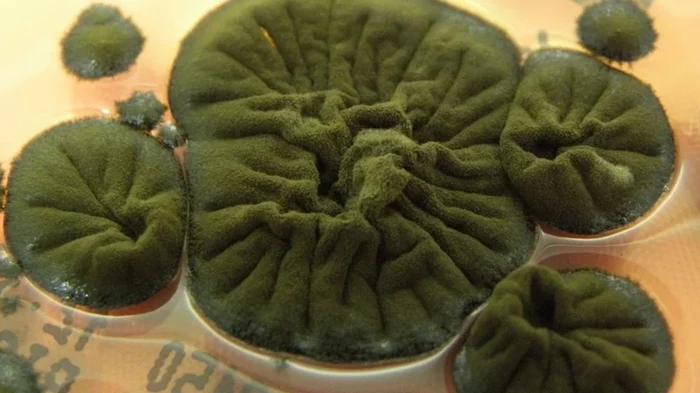

На стенах одного из самых радиоактивных зданий Земли найдена странная жизнь: питается излучением | |
Фото: Atlas of Mycology Образец был найден в Зоне отчуждения Чернобыля и, как считается, сумел развить невероятную способность
Исследователи только что обнаружили один из самых странных грибов в мире. Образец был найден в Зоне отчуждения Чернобыля и, как считается, сумел развить невероятную способность. Зона отчуждения Чернобыля, возможно недоступна для людей, однако за последние 40 лет после взрыва четвертого энергоблока Чернобыльской АЭС другие формы жизни не просто проникли сюда и выжили, но также адаптировались, чтобы процветать в столь суровых условиях, пишет Science Alert. Ученые считают, что это отчасти может быть связано с отсутствием людей. Но, по крайней мере, для одного организма ионизирующее излучение, сохраняющееся внутри окружающих реактор конструкций похоже стало преимуществом. Очень странны гриб ЧернобыляВ новом исследовании ученые обнаружили на внутренних стенах одного из самых радиоактивных зданий в мире очень странный черный гриб, который похоже процветает. Этот гриб называется Cladosporium sphaerospermum и некоторые ученые полагают, что его темный пигмент — меланин — позволяет ему использовать ионизирующее излучение посредством процесса, аналогичного тому, как растения используют свет для фотосинтеза. Этот предполагаемый механизм получил название радиосинтез. Еще более любопытным оказалось то, что ученые так и не могут объяснить, как и почему происходит. Теория, которую сложно доказатьРадиосинтез — это теория, которую трудно доказать. История берет свое начало в конце 1990-х годов, когда ученые под руководством микробиолога Нелли Ждановой из Национальной академии наук Украины начала полевые исследования в Чернобыльской зоне отчуждения. Ученые стремились выяснить, можно ли обнаружить какую-либо жизнь в укрытии вокруг разрушенного реактора. Команда была шокирована, обнаружив целое сообщество грибов, насчитывающее целых 37 видов. Примечательно, что эти организмы, как правило, были темно-черными и богаты пигментом меланином. C. sphaerospermum доминировал в образцах, демонстрируя при этом один из самых высоких уровней радиоактивного загрязнения. Радиофармаколог Екатерина Дадачова и иммунолог Артуро Касадеваль, оба работающие в Медицинском колледже Альберта Эйнштейна в США, возглавили группу ученых, которые обнаружили, что воздействие ионизирующего излучения на этот гриб не наносит ему вреда. Отметим, что ионизирующее излучение — излучение частиц, достаточно мощных, чтобы выбивать электроны из атомов, переводя их в ионные формы. Известно, что ионизация способна расщеплять молекулы, нарушая биохимические реакции и даже уничтожая ДНК. Однако C. sphaerospermum оказался на удивление устойчивым и даже лучше рос под воздействием ионизирующего излучения. Ученые также обнаружили, что ионизирующее излучение изменяет поведение грибкового меланина. В 2008 году ученые впервые предложили биологический путь, аналогичный фотосинтезу. Ученые пришли к выводу, что гриб, вероятно, поглощает ионизирующее излучение и преобразует его в энергию. В то же время меланин выполняет функцию, аналогичную функции поглощающего свет пигмента хлорофилла. В то же время меланин действует как защитный экран от более вредного воздействия этого излучения. Это предположение было подтверждено в исследовании 2022 года. И все же, реальный радиосинтез все еще лишь предстоит продемонстрировать. | |
|
01.12.2025 в 16:32 748 Наука | |
| Комментариев: 0 | |